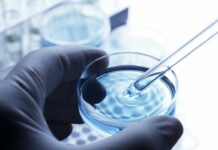
Dengue, il vaccino di Takeda approvato da Aifa e disponibile in Italia

Archivi Giornalieri: 27 Settembre 2023
Dalla Cisl un manifesto “per un lavoro a misura della persona”
ROMA (ITALPRESS) - Maggiori finanziamenti su istruzione e formazione, più orientamento scolastico e universitario, tirocini più mirati, attivare le politiche attive, salario minimo solo...
Sciame sismico nell’area dei Campi Flegrei, scossa di magnitudo 4.2
NAPOLI (ITALPRESS) - E' proseguito per tutta la notte lo sciame sismico iniziato dalle prime ore di ieri nell'area dei Campi Flegrei, a ovest...
Associazione mafiosa e spaccio di droga, 31 arresti in Sardegna
CAGLIARI (ITALPRESS) - I carabinieri del Ros (col supporto, in fase esecutiva, dei Comandi Provinciali Carabinieri di Cagliari, Nuoro, Oristano, Sassari, Milano, Torino e...
Dengue, il vaccino di Takeda approvato da Aifa e disponibile in Italia
ROMA (ITALPRESS) - Takeda ha annunciato che AIFA, Agenzia Italiana del Farmaco, ha approvato TAK-003, nome commerciale Qdenga, il vaccino tetravalente vivo attenuato per...
Salutequità e Apiafco “La psoriasi entri nel Piano Nazionale Cronicità”
ROMA (ITALPRESS) - Una persona su 10 con cronicità o multicronicità è affetta da psoriasi (si stima 1.8 milioni su 24 milioni) e colpisce...
Salutequità e Apiafco “La psoriasi entri nel Piano Nazionale Cronicità”
ROMA (ITALPRESS) - Una persona su 10 con cronicità o multicronicità è affetta da psoriasi (si stima 1.8 milioni su 24 milioni) e colpisce...
Occhiuto apre i lavori del “Calabria Digital Summit”
CATANZARO (ITALPRESS) - "Nell'ambito della trasformazione digitale c'è ancora tanto da fare, abbiamo però un ecosistema favorevole alle buone pratiche, c'è una ricchezza di...
Nasce Erion Textiles, Consorzio per la gestione dei rifiuti tessili
MILANO (ITALPRESS) - Assicurare una gestione efficiente del fine vita dei prodotti tessili finiti, diffondendo una sempre maggiore consapevolezza sulle opportunità offerte dall'economia circolare:...